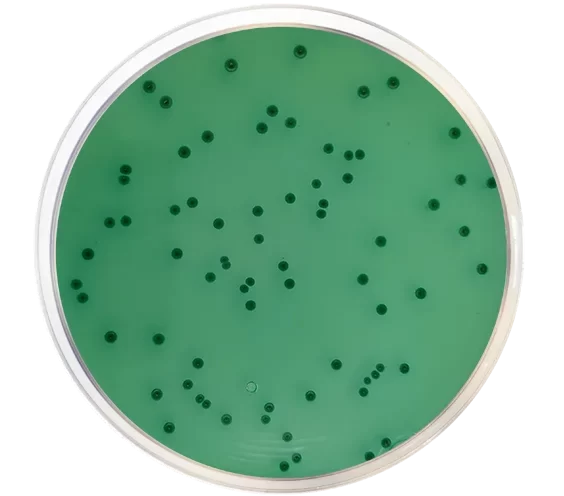
محیط کشت بیسموت سولفیت آگار

مقدمهای بر محیط کشت BSA (بیسموت سولفیت آگار)
باکتریهای سالمونلا (Salmonellae) از نظر طبقهبندی پیچیدهترین گروه باکتریها را در میان باکتریهای انتروباکتریاسه (Enterobacteriaceae) تشکیل میدهند. عفونت سالمونلای انسانی بیشتر در اثر مصرف غذا، آب یا شیر آلوده به فضولات انسان یا حیوان ایجاد میشود. انسانها تنها منبع سالمونلا تیفی (S. Typhi) هستند.
چهار نوع بالینی عفونت سالمونلا وجود دارد که عبارتند از: ورم معده و روده، وجود باکتری در خون یا عفونت خونی، تب روده و حالت ناقل. برای جداسازی و شناسایی اولیه باکتریهای سالمونلا (به ویژه سالمونلا تیفی) محیطهای کشت مختلفی به کار گرفته شده است. محیط کشت BSA (بیسموت سولفیت آگار) پربازدهترین این روشها است. این آگار با اصلاح محیط کشت Wilson و Blair برای جداسازی سالمونلا تیفی و سایر سالمونلاها به دست آمده و به ویژه برای جداسازی باکتریهای سالمونلای تخمیرکننده لاکتوز مفید است.
ترکیبات محیط کشت BSA
| ترکیبات | گرم بر لیتر |
| پپتون (Peptone) | 10 |
| HM Pepton B# | 5 |
| دکستروز (گلوکز) | 5 |
| دیسدیم فسفات (Disodium phosphate) | 4 |
| فروس سولفات (Ferrous sulfate) | 0.3 |
| نشانگر سولفیت بیسموت | 8 |
| برلیانت گرین (Brilliant green) | 0.025 |
| آگار | 20 |
pH نهایی: 0.2±7.7
اصول بیسموت سولفیت آگار
پپتون و HM پپتون B منابع کربن، نیتروژن، اسیدهای آمینه با زنجیره بلند، ویتامینها و فاکتورهای رشد ضروری هستند. دکستروز (Dextrose) منبع کربن است. دیسدیم فسفات تعادل اسمزی را حفظ میکند. نشانگر سولفیت بیسموت همراه با برلیانت گرین باکتریهای گرم مثبت و گرم منفی روده را مهار میکنند. سولفات آهن (Ferrous sulfate) در تشخیص تولید سولفید هیدروژن (hydrogen sulfide) کمک میکند. از نمونههای بالینی میتوان مستقیماً برای تلقیح بیسموت سولفیت آگار استفاده کرد. در مورد نمونههای غذایی، غنیسازی نمونه قبل از تلقیح انجام میشود.
سالمونلا تیفی، ﺳﺎﻟﻤﻮﻧﻼ انتریتیدیس (S. Enteritidis) و سالمونلا تیفیموریوم (S. Typhimurium) معمولاً به صورت کلنیهای سیاه رنگ با یک جلای متالیک (که ناشی از تولید سولفید هیدروژن و کاهش سولفیت به سولفید آهن سیاه میباشد) رشد میکنند. سالمونلا پاراتیفی A (Salmonella Paratyphi A) به صورت کلنیهایی به رنگ سبز روشن رشد میکند.
آمادهسازی و روش استفاده از محیط کشت BSA
- 33 گرم از آگار را در 1000 میلیلیتر آب مقطر معلق کنید.
- محیط را حرارت دهید تا به جوش آید و آگار کاملا حل شود.
- محیط را در اتوکلاو یا با استریلسازی جزئی، استریل نکنید. زیرا گرمای بیش از حد ممکن است حالت انتخابی محیط را از بین ببرد.
- محیط را خوب مخلوط کنید تا سوسپانسیون پخش شود و سپس آن را در چند پلیت (25 میلیلیتر محیط در هر پلیت) بریزید. اجازه دهید محیط در پلیت بدون سرپوش، جامد شود.
- پلیتها را قبل از استفاده خشک کنید، اما مراقب باشید که بیش از حد خشک نشوند.
- پلیتهایی که به صورت صحیح آماده شدهاند باید کدورت روان و کرم مانندی با رنگ زرد کاهی کم رنگ داشته باشند. هیچ روسوبی از نشانگر نباید وجود داشته باشد.
- پلیتها را با نمونه تلقیح کنید.
- محیطهای تلقیح شده را به مدت 48 ساعت در دمای 35 درجه انکوبه کنید و پس از 24 ساعت رشد کلنیهای را بررسی کنید. اگر پلیتها بعد از 48 ساعت رشد پایین کلنی یا عدم رشد آن را نشان دادند، 18 تا 24 ساعت دیگر محیط را انکوبه کنید.
نکته: حساسیت محیط تا حد زیادی به انتشار یکنواخت سولفیت بیسموت رسوب داده شده در ژل نهایی بستگی دارد که باید قبل از ریختن در پلیتهای پتری استریل، در محیط پخش شود.
تفسیر نتیجه محیط کشت BSA
| ارگانیسم | رشد |
| انتروباکتر آئروژنز (Enterobacter aerogenes) | رشد ضعیف. به رنگ قهوهای – سبز (بسته به چگالی تلقیح) |
| انتروکوکوس فکالیس (Enterococcus faecalis) | مهار رشد |
| اشریشیا کلی (Escherichia coli) | رشد ضعیف؛ به رنگ قهوه ای- سبز (بسته به چگالی تلقیح) |
| سالمونلا انتریتیدیس | رشد خوب و زیاد؛ به رنگ مشکی با یک درخشش متالیک |
| سالمونلا تیفی | رشد خوب و زیاد؛ به رنگ مشکی با یک درخشش متالیک |
| سالمونلا تیفی موریوم | رشد خوب و زیاد؛ به رنگ مشکی با یک درخشش متالیک |
| سالمونلا آبونی (Salmonella Abony) | رشد خوب و زیاد؛ به رنگ مشکی با یک درخشش متالیک |
موارد استفاده از محیط کشت BSA
- محیط کشت BSA برای جداسازی انتخابی و شناسایی اولیه سالمونلا تیفی و سایر سالمونلاها از مواد پاتولوژیک، فاضلاب، منابع آب، مواد غذایی و غیره توصیه میشود.
محدودیتهای محیط کشت BSA
- محیط کشت BSA ممکن است برخی از سویههای گونه سالمونلا را مهار کند. بنابراین نباید به عنوان تنها محیط کشت انتخابی برای این ارگانیسمها استفاده شود.
- همچنین این محیط در مقایسه با سایر محیطهای انتخابی، استفاده از تلقیح بزرگتر را ترجیح میدهد، زیرا دارای اثر مهارگری منحصر به فردی نسبت به ارگانیسمهای گرم مثبت و کلیفرمها (Coliform) میباشد.
- در مورد گونههای خاص سالمونلا، کلنیهای سیاه رنگ با یک درخشش متالیک در اطراف محل تلقیح سنگین مشاهده میشوند و کلنیهای جدا شده ممکن است رنگ سبز را نشان دهند.
- گونههای شیگلا (Shigella) به جز شیگلا فلکسنری ( flexneri) و شیگلا سونئی (S. sonnei)، غالبا در این محیط مهار میشوند.
- برخی از گونههای سالمونلا مانند Sendai، S. Berta، S. Gallinarum، S. Abortus-equi نیز در این محیط مهار میشوند.
جهت خرید و یا استعلام قیمت با ما تماس بگیرید یا در واتسپ پیام بزارید
همچنین بخوانید:
- محیط کشت DCA: ترکیب، اصول، روش آمادهسازی، نتایج و کاربرد
- برد پارکر آگار (Baird Parker Agar): ترکیب، اصول،آمادهسازی، نتایج و کاربرد
- اشدون آگار (Ashdown’s Agar): ترکیب، اصول، آمادهسازی، نتایج و کاربرد
- بروسلا آگار (Brucella Agar): ترکیب، اصول، روش آمادهسازی، نتایج و کاربرد
- اندو آگار (Endo Agar): ترکیب، اصول، روش آمادهسازی و کاربرد
مترجم: صادق حسینیکیا




